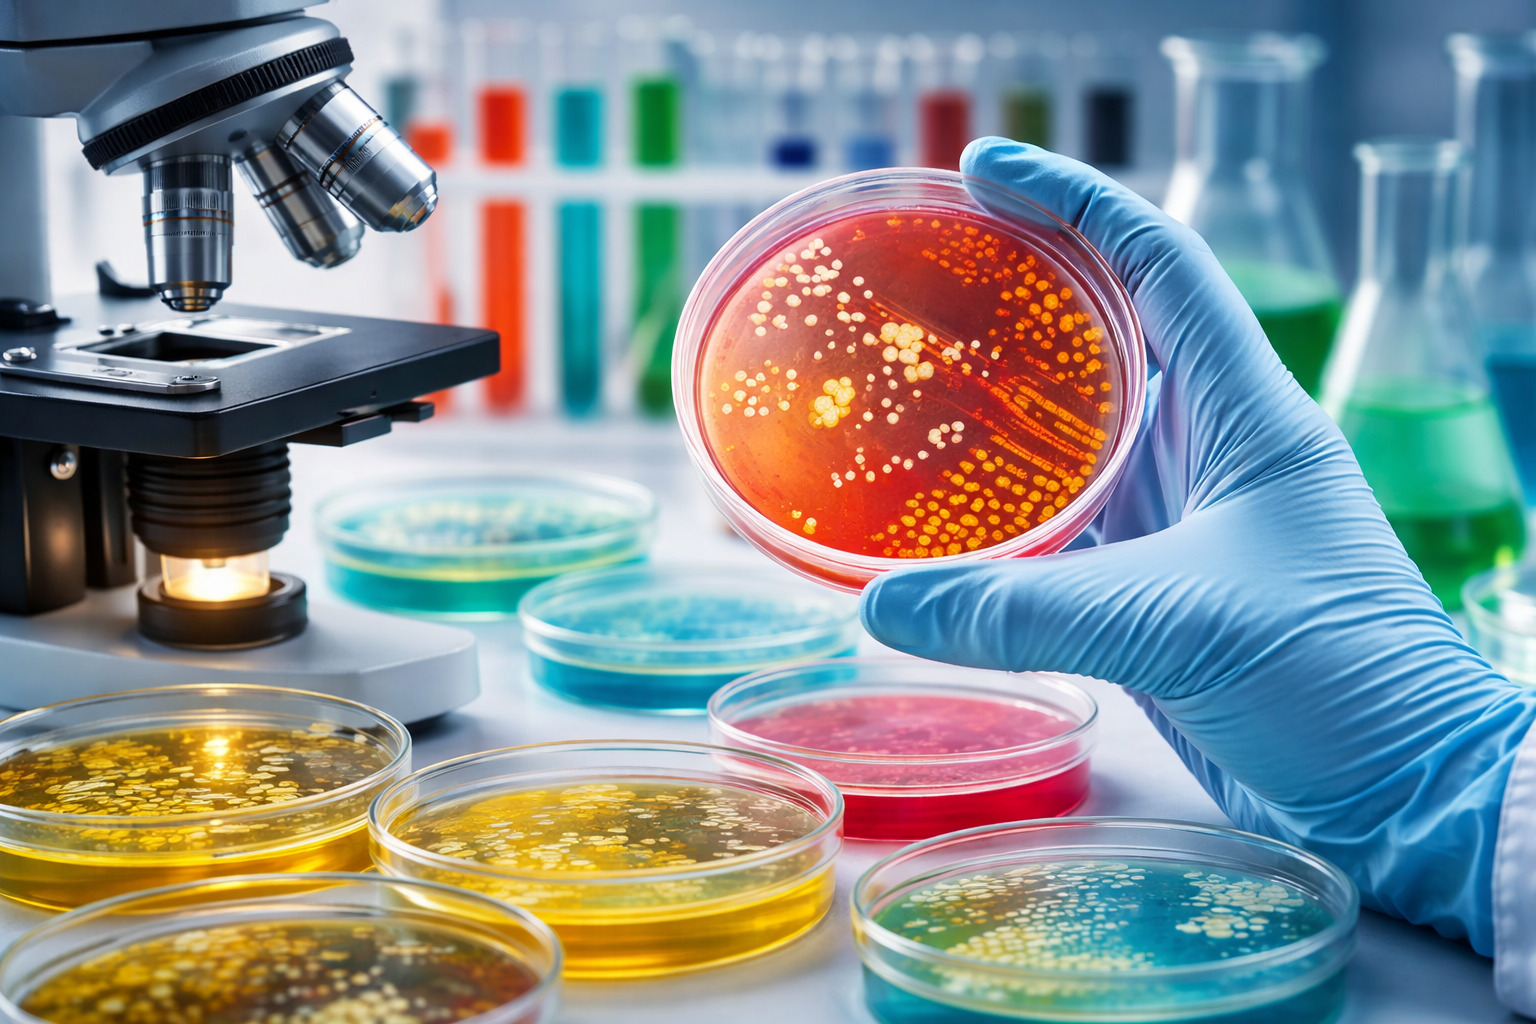

AGGIORNAMENTI
Cerca
Attualità
28 Marzo 2026 - 13:50
Ceppi microbici conservati (foto di repertorio)
Una ricchezza invisibile, ma decisiva per il futuro. Oltre 43.000 ceppi microbici conservati, catalogati e pronti a essere utilizzati per ricerca, industria e innovazione. È il cuore del progetto europeo SUS-MIRRI.IT, presentato all’Università di Torino, che rafforza la più grande infrastruttura italiana dedicata alle risorse microbiche.
Una rete che coinvolge 29 istituzioni di ricerca, tra cui l’Università di Sassari, e che rappresenta uno degli investimenti più importanti nel campo della bioscienza e della bioeconomia.
Il progetto potenzia MIRRI-IT, nodo italiano dell’infrastruttura europea MIRRI-ERIC, che coordina le principali collezioni microbiche del Paese. Tra queste spicca la collezione MBDS-UNISSCC dell’Università di Sassari, parte di un sistema che ha realizzato il più ampio catalogo nazionale di microrganismi: batteri, funghi filamentosi, lieviti, microalghe e virus vegetali.
Una vera e propria banca della vita microscopica, accessibile a università, centri di ricerca e imprese per sviluppare applicazioni biotecnologiche. Perché proprio i microrganismi rappresentano oggi una risorsa strategica: dall’agricoltura sostenibile alla sicurezza alimentare, fino allo sviluppo di nuovi farmaci e prodotti innovativi.
Il progetto non si limita alla catalogazione. Ha rafforzato concretamente la rete nazionale con 94 nuove strumentazioni scientifiche e 56 nuovi servizi avanzati di analisi microbica. Strumenti dedicati alla caratterizzazione genomica e fenotipica, allo studio dei microbiomi, alla bioinformatica e alla ricerca applicata nei settori ambientale, sanitario e agroalimentare.
Un salto in avanti che ha avuto anche un impatto diretto sulle persone: oltre 50 tra ricercatori, tecnici e dottorandi coinvolti, 34 corsi di formazione avanzata attivati e 15 programmi di accesso nazionale e internazionale ai laboratori della rete.
Le attività scientifiche hanno già prodotto più di cento pubblicazioni e numerose collaborazioni con il mondo accademico e industriale. Numeri che raccontano un sistema in crescita e sempre più interconnesso.
Il valore complessivo dell’investimento è di circa 17 milioni di euro, con il coinvolgimento di 15 istituzioni a livello nazionale.
\
A spiegare il ruolo strategico della collezione dell’Università di Sassari è Marilena Budroni, responsabile scientifica: «L'infrastruttura di ricerca MBDS-UNISSCC dell'Università di Sassari, con sede presso il Dipartimento di Agraria rappresenta un serbatoio di biodiversità in quanto sezione esterna della Banca Regionale di germoplasma, certificata ISO 9001:2015 e riconosciuta a livello internazionale».
E aggiunge: «È uno strumento fondamentale per l'innovazione in campo biotecnologico, agroalimentare e ambientale. Le risorse microbiche identificate, caratterizzate e conservate sono prototipi testabili su scala pilota e preindustriale e sono a disposizione di produttori e di portatori di interesse».
Non solo ricerca, ma anche trasferimento tecnologico e impatto sul territorio: «MBDS-UNISSCC offre servizi, consulenze e formazione, partecipa e promuove progetti di trasferimento tecnologico in collaborazione non solo con imprese che operano nel territorio ma anche con associazioni di categoria, associazioni del terzo settore, amministrazioni pubbliche».
Una rete invisibile che lavora sotto la superficie, ma che potrebbe ridefinire il modo in cui produciamo cibo, sviluppiamo farmaci e affrontiamo le sfide ambientali. Perché il futuro, sempre più spesso, passa da ciò che non si vede.
Edicola digitale
LA VOCE DEL CANAVESE
Reg. Tribunale di Torino n. 57 del 22/05/2007. Direttore responsabile: Liborio La Mattina. Proprietà LA VOCE SOCIETA’ COOPERATIVA. P.IVA 09594480015. Redazione: via Torino, 47 – 10034 – Chivasso (To). Tel. 0115367550 Cell. 3474431187
La società percepisce i contributi di cui al decreto legislativo 15 maggio 2017, n. 70 e della Legge Regione Piemonte n. 18 del 25/06/2008. Indicazione resa ai sensi della lettera f) del comma 2 dell’articolo 5 del medesimo decreto legislativo
Testi e foto qui pubblicati sono proprietà de LA VOCE DEL CANAVESE tutti i diritti sono riservati. L’utilizzo dei testi e delle foto on line è, senza autorizzazione scritta, vietato (legge 633/1941).
LA VOCE DEL CANAVESE ha aderito tramite la File (Federazione Italiana Liberi Editori) allo IAP – Istituto dell’Autodisciplina Pubblicitaria, accettando il Codice di Autodisciplina della Comunicazione Commerciale.